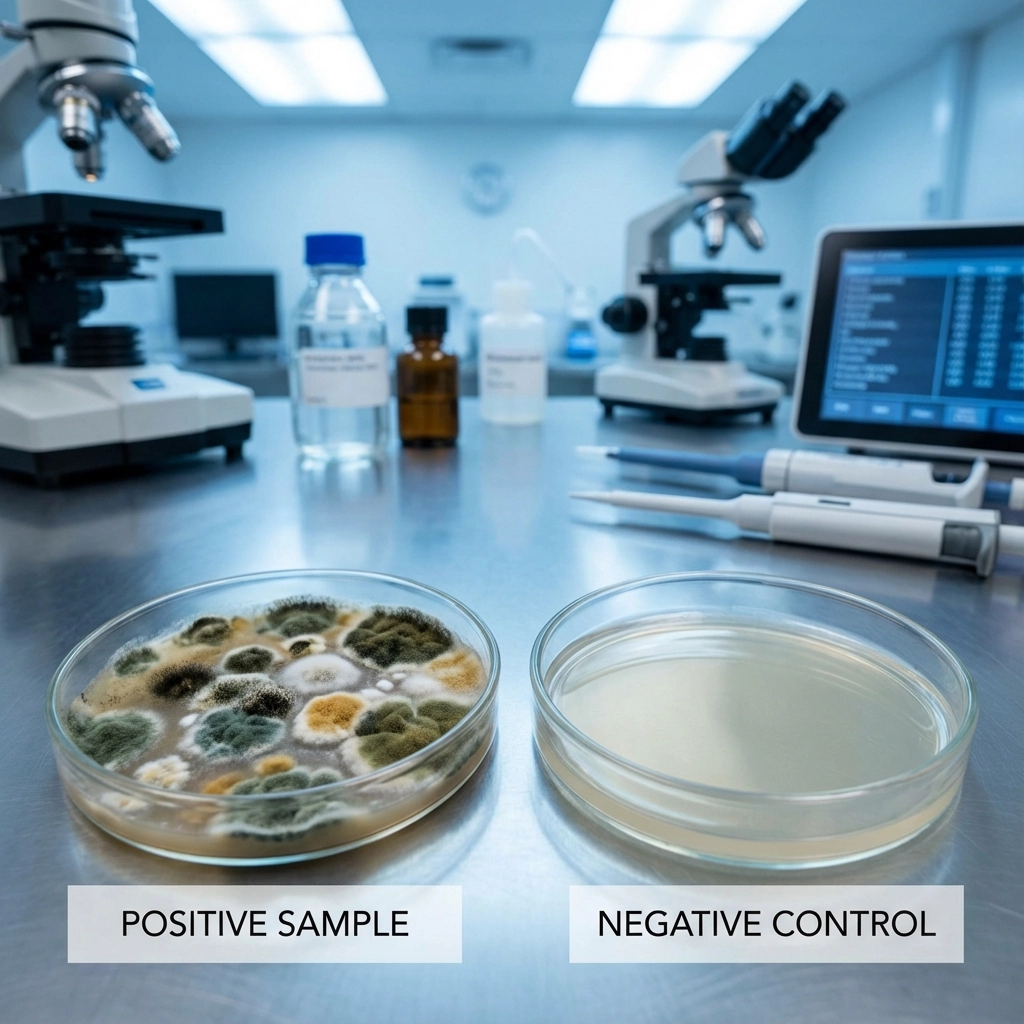
image_2

json Copy code
Look, I get it. You just got your mold test results back, and you're staring at a bunch of numbers, scientific names, and technical jargon that might as well be written in ancient Greek. After doing thousands of mold inspections across York County, I've seen that same confused look on homeowners' faces in Red Lion, Hanover, Spring Garden Township, and everywhere in between.
Here's the thing – mold test results don't have to be rocket science. Once you know what to look for, they're actually pretty straightforward. Let me break it down for you in plain English, so you can figure out whether you've got a real problem or just normal, everyday mold that's not worth losing sleep over.
First off, there are two basic ways we test for mold: air samples and surface samples. Think of air samples like taking the temperature of your house – they tell us what's floating around in the air you're breathing. Surface samples are more like checking specific spots where we suspect mold might be growing.

In York County homes, I typically recommend air samples because our humidity levels and older housing stock create perfect conditions for airborne mold spores. When I'm testing a basement in Dallastown or a crawl space in Stewartstown, air samples give us the big picture of what's really going on.
Surface samples are great when we can see visible mold or suspect growth in a specific area. If you've got that black stuff growing around your bathroom tiles or suspicious spots in your basement after one of our notorious York County heavy rains, a surface sample can tell us exactly what we're dealing with.
Here's where most people's eyes glaze over, but stick with me because this is important. Mold test results come back with measurements in "spores per cubic meter" (sp/m³). I know, I know – sounds fancy, but it's just counting how many mold spores are floating around in a box of air about the size of your refrigerator.
Generally speaking:
But here's the catch – and this is crucial – these numbers mean nothing without context. A reading of 800 sp/m³ in your living room might be totally normal if it's 1,200 sp/m³ outside. Remember, mold spores are everywhere in nature, especially here in south-central Pennsylvania where we've got plenty of trees, leaves, and moisture.

This is where the magic happens, and honestly, where most DIY test kits fall flat on their face. Professional mold testing always includes an outdoor "control" sample. We're comparing what's inside your house to what Mother Nature is throwing around outside.
If your indoor levels are similar to or lower than outdoor levels, you're probably fine. The mold spores are just drifting in from outside through normal air exchange – totally normal and not a health concern for most people.
But if your indoor levels are significantly higher than outdoor levels? That's when we start looking for an indoor source. Maybe it's that persistent leak under your kitchen sink, or perhaps your basement in Manchester Township is holding more moisture than it should after our last big storm.
Your report will list the types of mold found, usually with intimidating scientific names like Penicillium, Aspergillus, or Cladosporium. Don't let these scare you – most of these are common outdoor molds that you'd find in any backyard in York County.
Here's what I tell my clients: focus less on the scary names and more on the patterns. Are you seeing the same types indoors and outdoors? Probably not a big deal. Are you seeing different types indoors, or much higher concentrations of specific types? That's worth investigating.
The one that gets everyone worked up is Stachybotrys – the infamous "black mold." Yes, it can be concerning, but finding a few spores doesn't mean your house is condemned. It's all about concentration and whether you're seeing active growth.

After years of testing homes from York City to Shrewsbury, I've learned to spot the patterns that indicate real mold issues. Here are the red flags I look for:
Significantly elevated indoor levels: When indoor spore counts are 3-5 times higher than outdoor levels, especially for specific mold types, we've usually got an indoor moisture source.
Unusual mold types: Finding water damage indicators like Chaetomium or Stachybotrys indoors when they're not present outside often points to chronic moisture problems.
Consistent patterns across multiple rooms: If every room in your house shows elevated levels, you might have a whole-house humidity issue or problems with your HVAC system.
Hot spots: One room with dramatically higher readings than others usually indicates a localized moisture problem – maybe a plumbing leak or poor ventilation in that area.
Surface samples are more straightforward – they tell us exactly what's growing on that specific spot you're concerned about. The results come back as either "positive" or "negative" for mold growth, along with identification of the specific types found.
Here's what I've learned from testing surfaces in York County homes: just because we find mold on a surface doesn't automatically mean you have a major problem. Sometimes it's just surface mold from normal humidity fluctuations, especially in our climate where we can go from dry winter air to humid summer conditions pretty quickly.
The concerning results are when we find mold types that indicate ongoing moisture problems, or when the same problematic molds show up in multiple locations throughout the house.
Professional mold testing involves taking samples from multiple locations throughout your home. This gives us a map of what's happening where. In a typical York County home inspection, I might test the main living area, basement, a couple of bedrooms, and the outdoor control sample.
When I review results with homeowners, we're looking for patterns:
This location-specific data helps us pinpoint exactly where to focus our attention and what might be causing any issues we find.
Here's the part everyone really wants to know about. The truth is, most healthy people can tolerate normal levels of environmental mold without any issues. Problems typically arise when:
If you're experiencing symptoms like persistent coughing, congestion, or headaches that seem worse at home, elevated mold levels might be part of the equation. But remember, many health symptoms can have multiple causes, and mold testing is just one piece of the puzzle.
Not every mold test result requires immediate action. But certain findings definitely warrant professional attention:
Consistently elevated indoor levels: When multiple indoor samples show significantly higher spore counts than outdoor controls, especially for the same mold types, you've likely got an indoor moisture source that needs addressing.
Water damage indicators: Finding mold types associated with chronic water damage, like Chaetomium or high levels of Stachybotrys, usually means there's an ongoing moisture problem that needs professional remediation.
Failed post-remediation testing: If you've had mold remediation done and follow-up testing still shows elevated levels, the work wasn't completed properly or there's an ongoing moisture source that wasn't addressed.
In York County specifically, I often see problems stemming from our older housing stock, basement moisture issues, and the humidity swings we get throughout the year. Understanding these local factors can help you interpret your results in context.

Normal results: If your indoor levels are similar to or lower than outdoor levels, and you're not seeing any visual signs of mold growth, you're probably in good shape. Keep an eye on moisture levels and maintain good ventilation, especially during our humid Pennsylvania summers.
Slightly elevated results: If indoor levels are moderately higher than outdoor levels but not dramatically so, focus on moisture control. Check for minor leaks, improve ventilation, and consider using dehumidifiers during humid periods.
Significantly elevated results: Time to investigate further. Look for moisture sources, check for visible mold growth, and consider hiring a professional for a comprehensive inspection. This is especially important in York County basements, where moisture problems are common.
Water damage indicators present: If your results show mold types associated with chronic water damage, you need professional evaluation and likely remediation. Don't try to tackle this yourself.
Here's what I want you to remember: mold test results are just data points. They're most useful when interpreted alongside a visual inspection, moisture measurements, and an understanding of your home's specific conditions and history.
A single set of test results gives you a snapshot of conditions at one specific moment in time. Mold spore levels can fluctuate based on weather, seasonal changes, and activities in the home. That's why professional interpretation is so valuable – we can put your results in context based on local conditions and experience with similar homes in the area.
If you're still confused about your results or concerned about what they might mean for your family's health, don't hesitate to reach out for professional guidance. As someone who's been testing homes across York County for years, I can help you understand what your specific results mean for your specific situation.
Remember, knowledge is power. Understanding what your mold test results really mean puts you in control of making informed decisions about your home and your family's health. And that's a lot better than staring at a confusing report and wondering what the heck it all means.
Mastertech Environmental of York, PA. I'm your local expert in professional mold testing and inspection. With 17+ years of experience and trusted by thousands of homeowners, I can help you protect what matters most — your health and your home.